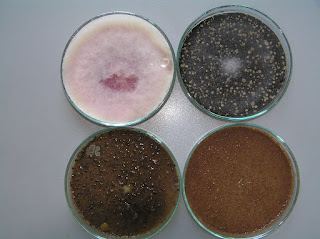

Ukryta prawda o cynamonie i nie tylko
Cynamon, mmm… Pachnący melancholijnie, zazwyczaj kojarzy się z miłymi chwilami: ze świętami, z babciną szarlotką, beztroskim dzieciństwem. Przyprawa egzotyczna, znana od dawien dawna, dodawana do ciast, budyniów, galaretek owocowych, kompotów, czekolady, wina grzanego, do zaprawiania tytoniu, a nawet do różnych preparatów kosmetycznych – perfum, past do zębów czy mydła. Ze względu na oryginalny wygląd – i nie mówimy tu o cynamonie zmielonym na proszek – wykorzystywana jest również jako ciekawy element ozdobny, np. w kuchennych zegarach ściennych z akcentami ziołowymi. Dużo tego, prawda? I bardzo dobrze.
Laska cynamonu to wewnętrzna część kory dwuletnich gałęzi cynamonowca cejlońskiego (Cinnamomum zeylanicum), drzewa z rodziny wawrzynowatych (Lauraceae), rosnącego dziko – jak można się domyślić – na Cejlonie. W naturze drzewo to może wyrosnąć do wysokości 20 metrów, natomiast w „kontrolowanych” uprawach cynamonowiec jest utrzymywany w postaci krzewiastej. Poza Sri Lanką uprawy cynamonowca można spotkać również w Indiach, południowych Chinach oraz na Wyspach Sundajskich, Seszelskich, Mauritiusie, Antylach, a także w Brazylii. Charakterystyczne właściwości zapachowe nadaje korze cynamonowej zawarty w niej olejek cynamonowy (1-4%), który składa się z – uwaga, tu mała „uczta” dla chemików – aldehydu cynamonowego, eugenolu, felandrenu, pininu, aldehydu benzoesowego, furfurolu, cymenu i innych substancji. No, to już wiemy skąd ten bukiet zapachowy. Ale czy w cynamonie chodzi tylko o zapach czy może kryją się w nim jeszcze inne zalety? Otóż, już starożytni Egipcjanie poznali się na cudownych właściwościach tej przyprawy, stosując ją na przykład przy... balsamowaniu zwłok. My raczej w ich ślady nie pójdziemy, no, ale skoro cynamon miał jakiś udział w konserwowaniu ciała po śmierci, to znaczy że powinien mieć właściwości bakterio- i fungistatyczne. Postanowiliśmy to sprawdzić.
Badania przeprowadzone przez studentów realizujących prace magisterskie w Katedrze Mykologii UW-M dowiodły właśnie takich, dobroczynnych właściwości tej popularnej przyprawy. Otóż, cynamon – dodany do pożywek w stężeniu 5% – silnie hamował rozwój różnych grzybów pleśniowych (Aspergillus flavus, Botrytis cinerea, Sclerotinia sclerotiorum, Penicillium sp., Rhizopus oryzae, różne gatunki z rodzaju Fusarium). Wymienione grzyby to patogeny roślin, powodujące choroby roślin uprawnych oraz tzw. choroby posprzętne czyli w przechowalnictwie plonów. Niektóre z nich (Aspergillus, Fusarium, Penicillium) produkują groźne mikotoksyny, kumulujące się w płodach rolnych. Hamujący wpływ na te grzyby wykazały również takie przyprawy, jak: czosnek, imbir, mięta i ziele angielskie.
Fusarium culmorum: u góry z lewej płytka kontrolna, obok - pożywka z miętą, na dole z lewej - pożywka z zielem angielskim i obok z imbirem
Fungistatyczne właściwości wyciągów z różnych roślin wykorzystywane są w postaci biopreparatów do walki z fitopatogenami, a także do wzmacniania odporności roślin. Na przykład preparat oparty na zmielonym czosnku, Bioczos BR, zalecany jest do ochrony roślin przed grzybami z rodzaju Penicillium, Nectria, oraz bakteriami z rodzaju Agrobacterium, Erwinia, Pseudomonas, jak również przed szkodnikami. Biosept 33SL to preparat oparty na wyciągu z grejpfruta, zawierający bioflawonoidy, cytrynian, limonen, glikozydy, witaminę C, polecany do ochrony roślin przed sprawcami wielu chorób pochodzenia wirusowego, bakteryjnego i grzybowego. Te łatwe w użyciu i dostępne w sklepach ogrodniczych, preparaty sprawdzają się szczególnie w małych gospodarstwach produkujących zdrową żywność, jak też na działkach ogrodniczych. Nie zanieczyszczają środowiska, są nieszkodliwe dla ludzi (zerowy okres karencji), zwierząt, pożytecznych owadów i ryb. Ekologiczne, zdrowe, tanie i skuteczne. Same zalety.
Rhizopus oryzae. Od lewej: płytka kontrolna, pożywka z czosnkiem oraz z cynamonem
A swoją drogą, czy wasze babcie też sypały ciut za dużo cynamonu do szarlotki? Czyżby wiedziały o właściwościach tej przyprawy? Tak czy inaczej, te cynamonowe szarlotki na pewno nie pleśniały. A więc ze śmiałością Magdy Gessler przyprawiajmy, co się da. Cynamonem, czosnkiem, imbirem, a efekt... bezgrzybowy gwarantowany!
Tekst i zdjęcia Ewa Sucharzewska

Komentarze (0):
Prześlij komentarz
Subskrybuj Komentarze do posta [Atom]
<< Strona główna